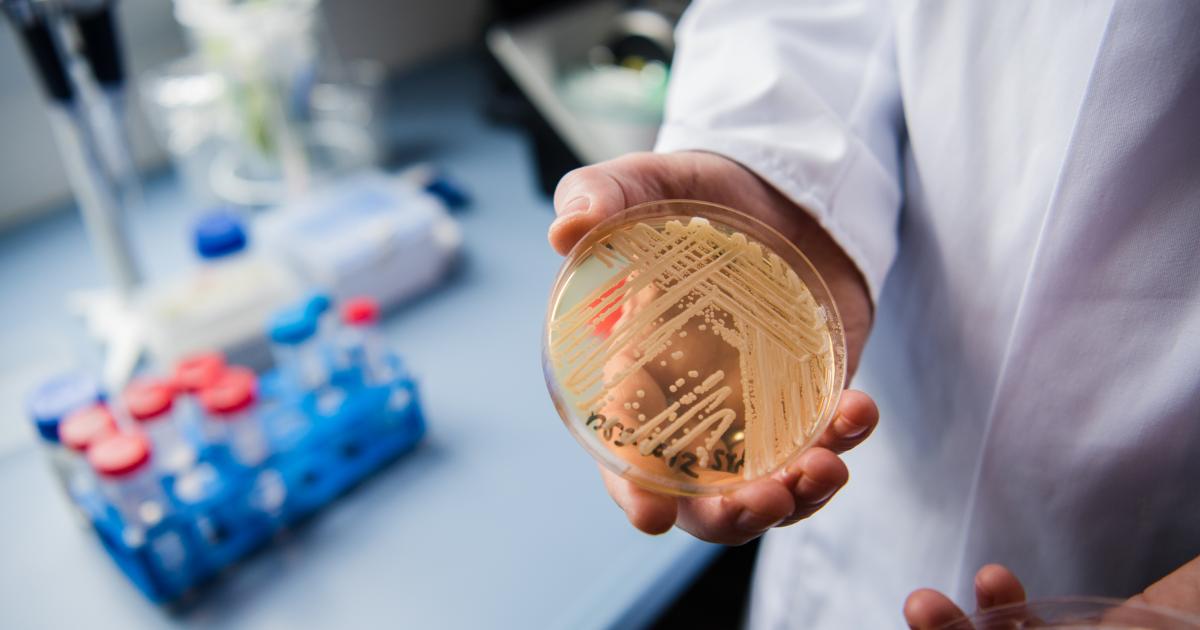

La OMS alerta seriamente de 'Candida auris': un virus que suele matar en 90 días
La enfermedad, que ha comenzado a expandirse de forma masiva por EE.UU, mantiene en alerta a la OMS.

Las principales organizaciones de la salud se encuentran en alerta tras la expansión descontrolada de la enfermedad Candida auris por más de 50 estados de los Estados Unidos.
Se trata de una enfermedad que resiste a los medicamentos y que está suponiendo una amenaza seria por su facilidad de transmisión, síntomas y su potencial tasa de mortalidad en caso extremos.
El hongo Candida auris es un microorganismo potencialmente mortal, y cuya propagación en EE.UU ha aumentado en los útlimos tres años de manera considerable, según apunta la revista Annals of Internal Medicine, debido a su 'ultra' resistencia a las equinocandinas, el fármaco principal para combatir este tipo de infecciones.
Los Centros para el Control y Prevención de Enfermedades de EE UU (CDC, por sus siglas en inglés) ya han dado el aviso. En 2021 los casos aumentaron un 200%, pasando de los 500 diagnosticados en 2019 a 1.474 en apenas dos años, mientras que en 2022, aumentaron a 2.377.
Primera alerta de la OMS
Desde el máximo organismo internacional de la salud, lo señalan como una "amenaza urgente" debido a la poca o nula efectividad de numerosos fármacos para frenar su expansión.
Un problema añadido es su facilidad a la hora de contraerlo, ya que se propaga fácilmente a través de centros de atención médica. Además, puede no mostrar síntomas, algo que impide una fácil detección y provoca que pueda expandirse fácilmente de una persona a otra.
A finales de 2022, tanto la CDC como la OMS ya avisaron del problema: "Representan una gran amenaza para la salud pública, ya que son cada vez más comunes y resistentes al tratamiento con solo cuatro clases de medicamentos antimicóticos actualmente disponibles", afirmó la OMS.
¿Por qué es tan peligroso?
El género Candida presenta varias especies de hongos, siendo esta una de ellas. Se trata de uno de los pocos que causa candidiasis en humanos, siendo paradójicamente los centros médicos el lugar de mayor exposición para las personas.
Esta puede ser invasiva, que afecta al torrente sanguíneo, sistema nervioso y órganos internos, y puede llegar a provocar candidiasis oral y vaginitis, llegando a casos de candidemias, potencialmente mortales.
Según los datos recabados, desde el momento en el que se contrae la enfermedad pueden transcurrir 90 días hasta el fallecimiento. De hecho, la complejidad de esta enfermedad, como bien apunta Meghan Lyman, puede provocar múltiples problemas de salud, por lo que en muchos casos, el hongo no es la causa principal de la muerte.
Según los expertos del CDC, la pandemia ha podido acelerar la propagación de la enfermedad, algo que provoca que sea de imperiosa necesidad detectarlo con la mayor rapidez y precisión posible.